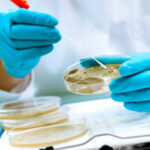
Escola japonesa verifica a roupa interior dos alunos e quem não cumprir as regras é punido

Uma escola japonesa ficou no centro de uma polémica depois de ter vindo a público que obrigava os seus alunos a mostrar a roupa íntima. O diretor já fez um pedido de desculpas.
Os alunos do primeiro ano do ensino secundário da escola Yamato, na província de Saga, iniciaram as aulas na semana passada – e com direito a uma prática considerada invasiva.
Os estudantes foram convidados a fazer uma fila para que a sua roupa interior fosse verificada antes de entrarem na escola. A ideia é que os alunos levantem a camisa alguns centímetros para que os professores do mesmo sexo possam confirmar se estes estão a usar uma camisola interior.
Segundo a VICE, a prática é comum em escolas públicas japonesas de todo o país. Porém, os alunos e os pais têm mostrado cada vez mais indignação perante esta e outras regras que os jovens têm de cumprir. Este conjunto de regulamentações são conhecidas como buraku kosoku.
Durante os anos 70 e 80, as regras buraku kosoku foram introduzidas para conter os casos de violência e bullying estudantis. As normas podem ditar o comprimento do cabelo dos alunos, a cor das meias, da roupa íntima e o comprimento do uniforme. As explicações para estas regras podem variar, desde o respeito à tradição até às preocupações com a saúde dos alunos – como é o caso da escola de Yamato.
Na passada sexta-feira, o tema ganhou algum destaque nas redes sociais e em alguns meios de comunicação, sendo que a medida acabou por ser duramente criticada por invadir a privacidade dos alunos.
Neste sentido, Kenji Koga, diretor da escola em questão, acabou por fazer um pedido de desculpas público a todos os alunos que foram sujeitos a esta prática. “Entendo que os deixamos muitos desconfortáveis. Foi inapropriado”, referiu em declarações à VICE.
Também o Conselho de Educação da cidade de Saga, onde está localizada a escola, recebeu algumas queixas após as noticias sobre o tema ganharem destaque.
“Os tutores, assim como os residentes da cidade, têm telefonado para dizer que a verificação da camisa é um exemplo de poder e assédio sexual. É um exemplo de violação dos direitos individuais dos alunos, e aconselhamos a escola a interromper esses métodos imediatamente”, destacou Katsuo Yonekura, representante do conselho em conversa com a VICE.
Depois do pedido de desculpas público, Koga garantiu que a escola suspendeu temporariamente a verificação de camisolas interiores, ainda assim, o responsável explicou que o objetivo desta prática é garantir que quando os alunos suam os seus uniformes não ficam sujos, como tal, é importante usar uma camisola interior para que estes não fiquem “pegajosos”.
O diretor referiu ainda que, por norma, os alunos do segundo e terceiro ano raramente são sujeitos a verificações, pois presume-se que já conheçam as regras vigentes. No entanto, os estudantes do primeiro ano – muitos dos quais nunca usaram uniforme antes – são mais propensos a violar as regras.
Apesar de ter havido um pedido de desculpas e um reconhecimento público de que esta prática não será a mais adequada, esta ainda não foi totalmente suspensa da escola.
Assim, embora os castigos severos sejam raros, os alunos podem ser repreendidos caso quebrem as regras.
Ana Isabel Moura, ZAP //